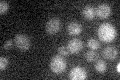
YDL217C

View description
Essential core component of the mitochondrial TIM22 complex involved in insertion of polytopic proteins into the inner membrane; forms the channel through which proteins are imported
Localization:
Intensity:
Fold change:
Significance:
-
C’ GFP library in SD

below threshold14.55 -
N' NOP1pr-GFP in SD

N/A0 -
N' TEF2pr-mCherry in SD

N/A0 -
N' NATIVEpr-GFP in SD

N/A0 -
N' TEF2pr-VC and Cyto-VN in SD

N/A0 -
C’ GFP library in SD+DTT

cytosol14.91.02No -
C’ GFP library in SD+H2O2

cytosol14.530.99No -
C’ GFP library in Starvation Media
cytosol16.721.14No -
C’ GFP library on the background of Pup2-DaMP

below threshold -
C’ GFP library on the background of CCT mutant

below threshold14.4640.993947No
